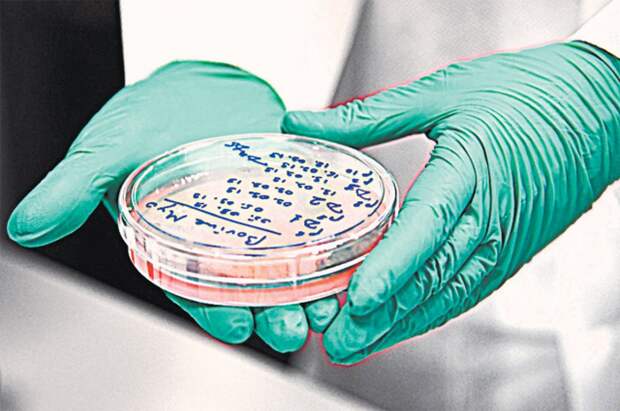

Заместитель министра промышленности и торговли Михаил Юрин ответил на вопрос, могут ли в России в ближайшее время разрешить продажу искусственного мяса.
«Мы пока недостаточно понимаем последствия употребления альтернативного мяса. Нужно время, чтобы изучить этот вопрос, и уже только после этого можно думать над разрешением продаж», — заявил Юрин в интервью «Российской газете».
При этом он отметил, что в России существует технология получения альтернативного мяса.
В августе в Китае заработал первый завод по производству искусственного мяса. Производитель рассчитывает продавать свою продукцию также в США и Сингапуре, где разрешено реализовывать продукты, выращенные в лаборатории.
За соответствующим разрешением компания обратится в эти страны уже в текущем году. На международный рынок китайская фирма планирует выйти к 2025 году.
Свежие комментарии